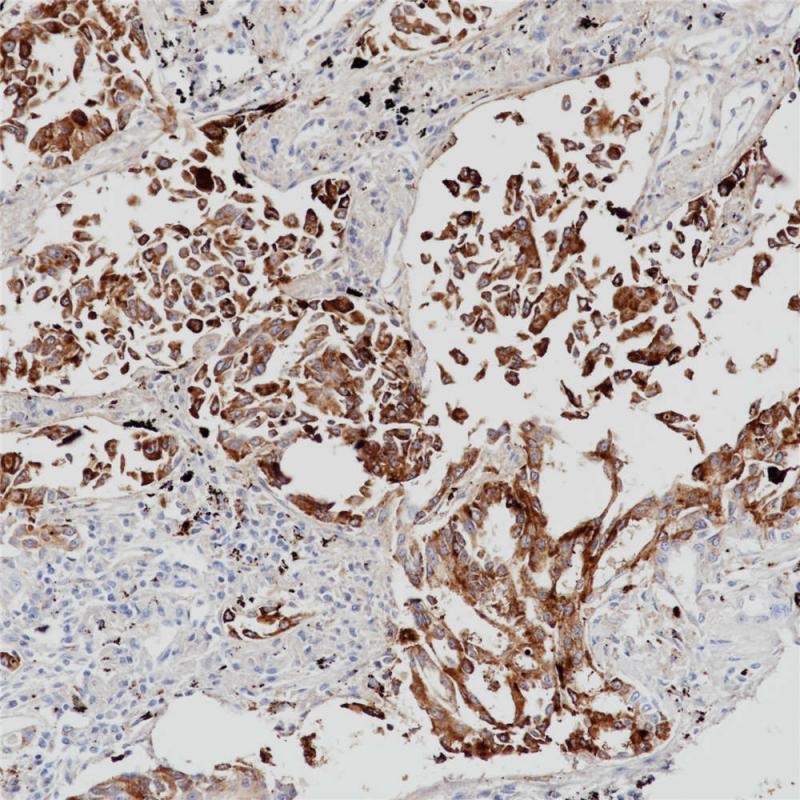
肺腺癌 Napsin A (BP6083) 染色

产品中心

肺腺癌 Napsin A (BP6083) 染色
肺腺癌 Napsin A (BP6083) 染色
Napsin A 重组兔单克隆抗体
Napsin A是一种含有420个氨基酸的胃蛋白酶样天冬氨酸蛋白酶,主要在肺和肾中表达。 在肺中,Napsin A在由TTF-1调节的II型肺泡细胞中表达,并参与生成表面活性蛋白B。肺泡内巨噬细胞含有Napsin A,这是吞噬作用的结果。 在肾脏中,Napsin A在近曲小管中表达,参与溶酶体蛋白质的分解代谢。 Napsin A在肺腺癌与鳞状细胞癌的鉴别诊断中非常重要,常与TTF-1,CK5和p63联用。 对于未知来源的腺癌,NapA和TTF1可辅助鉴别肺起源,NapA和PAX 8辅助鉴别肾起源。
Specifications
- 目录号
- BX50078
- 克隆号
- BP6083
- 阳性对照
- 肺腺癌
- 亚细胞定位
- 细胞质
- 组织类型
- FFPE
- 修复方式
- HIER
- 稀释比
- 1:100-1:200
- 规格
- 100μl/vial, 1ml/vial
- 用途
- RUO
Reference
1.Agackiran Y, Ozcan A, Akyurek N, Memis L. Appl Immunohistochem Mol Morphol. 2012 Jul;20(4):350-5.
2.Chernock RD, El-Mofty SK, Becker N, Lewis JS Jr. Am J Surg Pathol. 2013 May 15.


